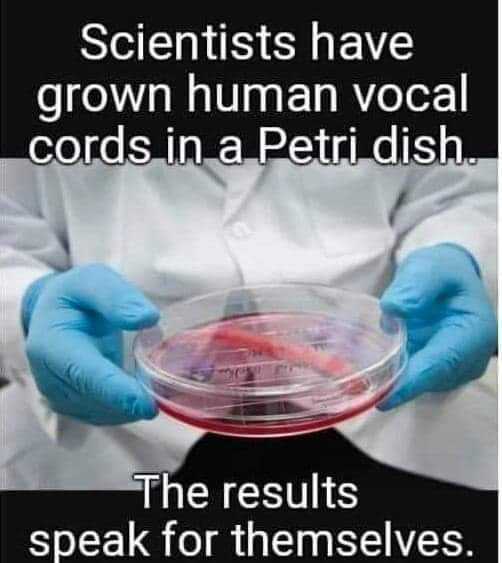

Table of Contents
This regular daily post is the place to joke and banish negative thoughts.





This regular daily post is the place to joke and banish negative thoughts.

If you have a great Youtube, Rumble or Vimeo video to share send it to videos@goodoil.news If you're loving this trusty, straight-up news on Kiwi politics and beyond, why not become a paid member, eh? Unlock exclusive yarns, podcasts, vids, and in-depth analysis—your
If you have a great Youtube, Rumble or Vimeo video to share send it to videos@goodoil.news
If you have a great Youtube, Rumble or Vimeo video to share send it to videos@goodoil.news If you're loving this trusty, straight-up news on Kiwi politics and beyond, why not become a paid member, eh? Unlock exclusive yarns, podcasts, vids, and in-depth analysis—your